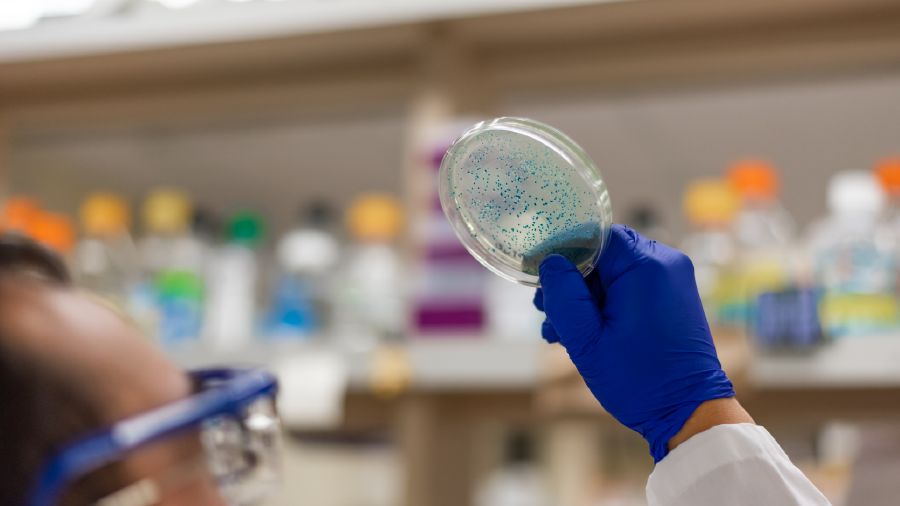
Yapay tatlandırıcılar, mikroorganizmaları da etkiledi

- Anasayfa
-
Medya
- Kur'an-ı Kerim Hatimleri
- Kur'an Programları
- Hadis - Sünnet
- Sohbetler
- Sözün Özü; Mahmud Esad Coşan’dan
- Dua
- İmam Buhari
- Varoluş Sebebimiz
- Eğitim - Aile
- Kültür
- Sağlık
- Edebiyat
- Hayat
- Çevre
- İnceleme - Araştırma
- Kritik Analitik Düşünme
- Sesli Kitaplar
- Audio Book
- Mehmed Zahid Kotku Anma
- Mahmud Esad Coşan Anma
- Muharrem Nureddin Coşan
- Hicrî Yıl
- Mevlid
- Üç Aylar
- Hac - Kurban
- Bayramlar
- Şeyh Şamil
- Muhammed ALİ
- Müzik
- VİDEOLAR
- Tell Me About Islam
- Galeriler
-
Haberler
- Güncel
- Ekonomi
- Türkiye
- Dünya
- Yaşam
- Eğitim
- Sağlıklı Yaşam
- Çevre
- Seyahat
- Dosya Haber
- İslam Diyarları
- Kritik Analitik Düşünme
- AKRA'dan Haberler
- Kültür Hazinemiz
- Püf Noktası
- Enerji
- Kur'an'dan Haber Var
- Ramazan
- Aile
- Doğal Tarifler
- Sivil Savunma
- Hac - Kurban
- İletişim
- Son Peygamber
- Varoluş Sebebimiz
- Yerel Haberler
- Tüm Haberler
- AKRA
- Araçlar
| İMSAK | GÜNEŞ | İŞRAK | ÖĞLE | İKİNDİ | AKŞAM | YATSI |
|---|---|---|---|---|---|---|
| 04:03 | 05:46 | 06:31 | 13:06 | 16:59 | 20:15 | 21:51 |
Gıda katkı maddeleri niçin kullanılıyor?
Gıda katkı maddeleri, en geniş anlamıyla gıdalara eklenen maddelerdir. “Gıdaları renklendirmek, tatlandırmak veya korunmasına yardımcı olmak gibi belirli teknolojik fonksiyonları gerçekleştirmek için gıdalara eklenen maddeler” olarak tanımlanmaktadır.
Dünya nüfusunun artması ile beraberinde yiyecek ihtiyacı da artıyor. Bunun yanında insanların çoğu yiyeceklerini kendisi üretmeyip hazır olarak satın alıyor. Gıda sanayisinin gelişmesi ve işlenmiş gıda üretiminin artmasına bağlı olarak gıda katkı maddelerinin kullanımı da artış gösteriyor.
Gıda katkı maddeleri başlıca beş amaçla kullanılıyor. Bunlar:
1. Ürünün kıvamını sağlamak
2. Besin değerini korumak veya artırmak
3. Lezzetini ve sağlığa yararlı halini muhafaza etmek
4. Asitlik veya alkaliliğin(bazlığın) sağlanmasını veya kontrol edilmesini temin etmek
5. Lezzeti artırmak veya arzu edilen rengi vermek

Gıda katkı maddeleri neden önemli?
Gıda katkı maddeleri iki açıdan önemli: Birincisi inanç ve bireysel tercihlere uygunluğu, ikincisi sağlığa etkileri.
İnanç ve bireysel tercihlere uygunluğu açısından katkı maddelerinin elde edildiği kaynaklar ve üretim sürecinde maruz kaldığı unsurlar önemlidir. Bazı inançlarda yiyecek ve içeceklerin bir kısmı yasaklanmıştır. Yasaklanan yiyeceklerden elde edilen katkı maddeleri de bu dinin mensuplarınca tüketilmemektedir. Dinî inanç yanında bireysel beslenme tercihi de katkı maddelerini önemli kılmakta. Vejetaryenler (hayvan eti yemeyenler) ile veganlar (hayvan eti yanında süt ve yumurta gibi hayvansal ürünleri de yemeyenler) de katkı maddelerini önemsemekte. Bu kişiler hayvansal kaynaklı katkıları içeren gıdalardan uzak durmayı tercih etmekte.
Katkı maddelerinin elde edildiği dört temel kaynak var: Bitkisel kaynaklar, hayvansal kaynaklar, mikrobiyal fermentasyon ve sentetik üretim.
Katkı maddelerinin sağlık üzerine olumsuz etkileri tüketiciler arasında ciddi bir endişe kaynağı. Gıda katkı maddeleri Gıda Kodeksine uygun şekilde tüketilirse ciddi bir olumsuzluk beklenmemekte. Çünkü katkı maddeleri izin verilen miktarda tüketilmesi orta derecede güvenli kabul edilir. Yüksek düzeyde güvenlik isteyen tüketiciler ise katkı maddelerine daha fazla dikkat etmelidirler. Çünkü katkı maddeleri kodekse uygun şekilde tüketilse bile bazı hastalıkların oluşmasına veya şiddetlenmesine sebep olabilir.
Gıda katkı maddeleriyle ilişkilendirilen hastalıklar

Gıda katkı maddelerinin zararlı etkilerinden korunmak için neler yapılmalı?
Gıda katkı maddeleri sağlık açısından bazı riskler taşıyabilir. Ancak günümüz koşullarında bunlardan tamamen kaçınmak ve tamamen doğal beslenmek neredeyse imkânsız hale gelmiştir.
Gıda katkı maddelerine en az seviyede maruz kalmak için birtakım yollar izlenebilir:
Öncelikle gıda katkı maddesi içermeyen, doğal gıdalar tercih edilmeli
En güzeli mümkün olduğunca doğal gıdaları tercih etmek. Doğal gıda derken öncelikle işlenmemiş gıdalar kastedilmekte. Örneğin salam, sosis ve sucuk gibi et ürünleri yerine etin kendisi tercih edilebilir. Reçel alırken içinde gıda boyası olmayan, içerik olarak evde yapılan ile aynı olan bir marka tercih edilebilir. Bu da doğal bir ürün olur. Tüm gıda çeşitlerinde katkısız ürün bulmak imkânsız olsa da bazı çeşitlerde mümkündür.
“Riskli” katkı maddelerini içermeyen gıdalar tercih edilmeli
Aranılan ürünün tüm markaları katkı maddeleri içeriyorsa tartışmalı veya riskli katkı maddelerini daha az içerenler tercih edilmeli. Örneğin meyve suyu seçerken markanın bir tanesi tatlandırıcı olarak sukroz yani çay şekeri kullanmış, diğeri aspartam yani yapay tatlandırıcı kullanmış olsun. Aspartam, üzerinde tartışmalar devam eden yani tartışmalı bir tatlandırıcı türü. Dolayısıyla bu iki meyve suyu içinde diğer katkı maddeleri açısından bir fark yoksa tartışmalı bir katkı maddesi olan aspartam içermeyen tercih edilebilir.
En az katkı maddesi içeren ürün tercih edilmeli
Eğer aranılan ürünün tüm markaları katkı maddesi içeriyorsa katkı maddesi en az olan tercih edilebilir.
Tüketici tercihleri üreticilere bildirilmeli
Üretici firmalar tüketici tercihlerini önemserler, önemsemek zorundalar. Çünkü ürünlerini satın alacak olan tüketicilerdir. Bilinçli tüketiciler her zaman üretici firmaları yönlendirmekte. Tüketici tercihlerine göre üretici firmalar ürün içeriklerini değiştirmekte. Birçok ülkede tüketicinin katkısız veya daha az katkı içeren gıdaları tercih etmesi, üreticileri daha az katkı maddesi kullanmaya itiyor. Hatta bazı ülkelerde sadece katkı maddesi içermeyen veya tartışmalı katkı maddelerini içermeyen gıdalar üreten firmalar kuruluyor. Ülkemizde de zaman içerisinde tüketici bilincinin gelişmesi, üretici firmaların politikalarına olumlu olarak yansıyacaktır. Bu sebeple ürün tercihleri üreticilere bildirilmeli.
Gıda denetimine destek olunmalı
Üretici firmaların uyarılması veya takdir edilmesinin yanında, ürünlerin denetiminden sorumlu yetkili merciler de haberdar edilebilir. ALO 174 Gıda Hattı aranabiliyor. “En iyi denetçi tüketicinin kendisidir” düşüncesinden hareketle, tüketiciler denetime davet ediliyor.
© İzinsiz ve kaynak gösterilmeden kullanılamaz.

8 soruda alerji ile ilgili merak edilenler

Ramazan’a hazır mıyız?

Mahmud Es‘ad Coşan‘ın Hayatı - YÂD Özel

Hazırlamış olduğum ve sitenize gönderdiğim/ teslim ettiğim, tamamen orjinal ve bana ait olan, projemin/görüntü veya kaydımın, AKRA MEDİA tarafından kendisine ait kablolu/karasal/uydu, şifreli/şifresiz, free/paralı TV, video, DVD, VCD,VHS ,radyo, kaset, sinema ve sair mevcut yada ortaya çıkacak her türlü İşaret, ses ve /veya görüntü nakline yarayan araçlarla umuma iletim hakkı ve tüm internet siteleri ve sosyal medya platformlarında yayınlamasına, çoğaltma hakkı, yayma hakkı, işleme hakkı ve temsil hakkının kullanılmasına süresiz olarak müsaade ediyorum.
Projemin/görüntü veya kaydımın, bant, CD, VCD, DVD, GSM, MP3 Player, dijital kayıt vb. tüm yollarla kayıt, çoğaltma ve dağıtım haklarını, bilişim veya iletişim ortamında görüntülenmesini, iletilmesini, okunmasını, izlenmesini, dinlenmesini vb. interaktif veya normal CD, VCD, DVD, GSM, MP3 Player vb. şekilde basılarak veya ses kayıtlarının metin haline getirilip kitap olarak piyasaya sunulmasını sağlayacak her türlü materyal üzerine kaydı ile çoğaltılması, kullanılması, işlenmesi, yeniden ve genişletilmiş şekilde sesli, yazılı ya da görüntülü yayın haklarını, bu suretle de çoğaltılarak kullanılması, dağıtılması, pazarlanması vb. fikri, mali ve manevi haklarımın tamamını, programda gerekli görülen değişiklikleri yapma haklarımı bila bedel olacak şekilde, AKRA.MEDİA sitesine ve bu site'nin yetkilisi ve sahiplerine devir ve temlik ettiğimi, beyan, kabul ve taahhüt ederim.
 Açık 22°C
Açık 22°C

 Kıble Bulucu
Kıble Bulucu Harem-i Şerif Canlı Yayın
Harem-i Şerif Canlı Yayın

Aile & Eğitim
Aile & Eğitim

 Sohbet
Sohbet
 Kur'an & Sünnet
Kur'an & Sünnet
 Kültür
Kültür